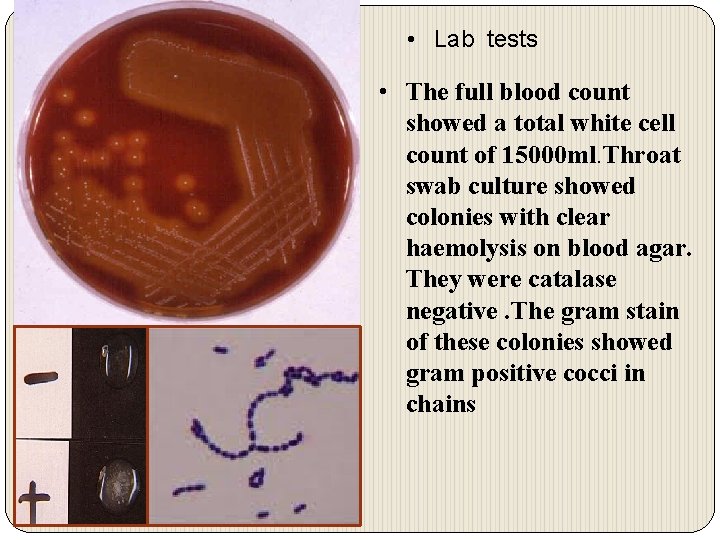
• Lab tests • The full blood count showed a total white cell
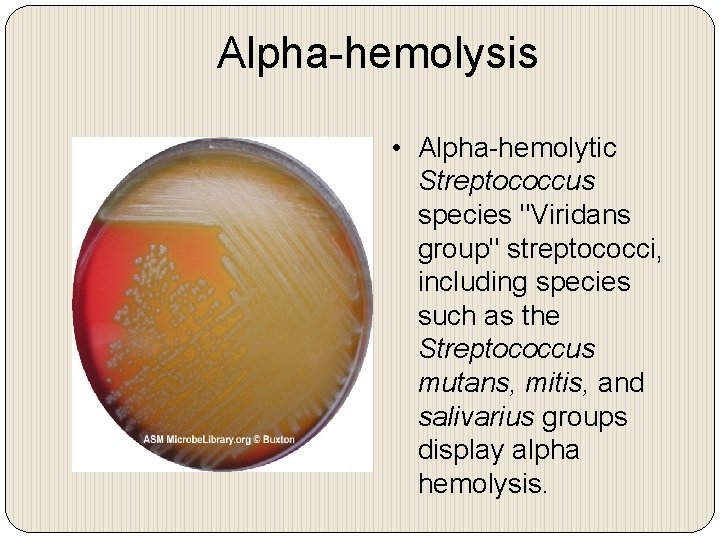
Alpha-hemolysis • Alpha-hemolytic Streptococcus species "Viridans group" streptococci, including species such as the Streptococcus
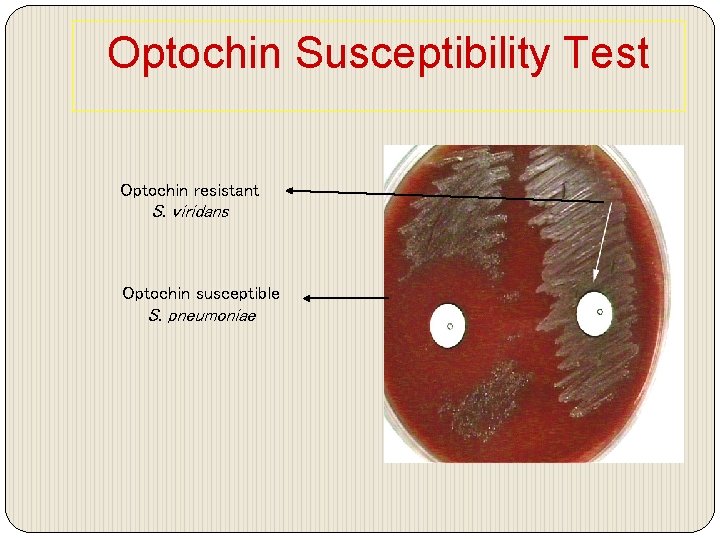
Optochin Susceptibility Test Optochin resistant S. viridans Optochin susceptible S. pneumoniae
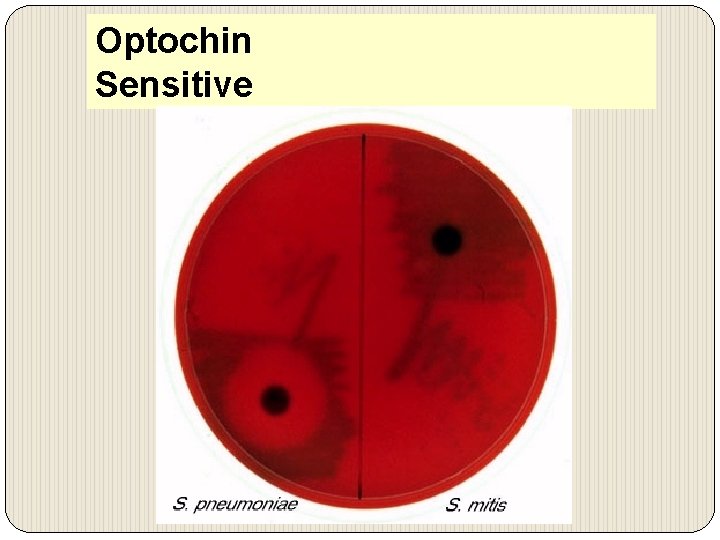
Optochin Sensitive
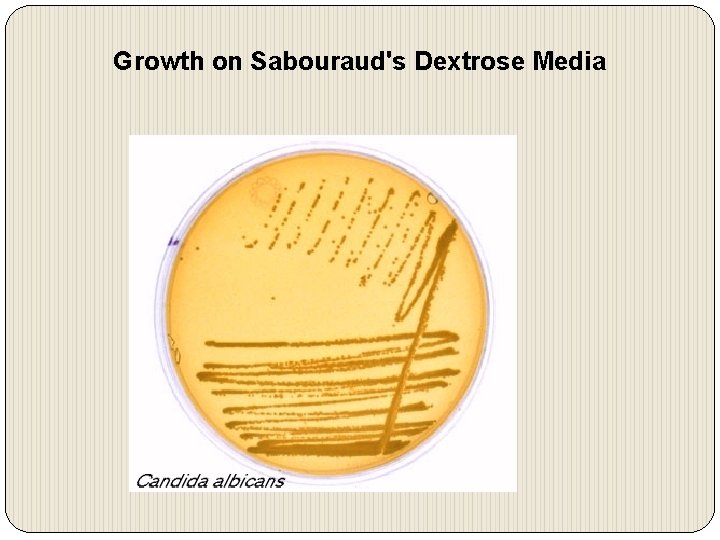
Growth on Sabouraud's Dextrose Media
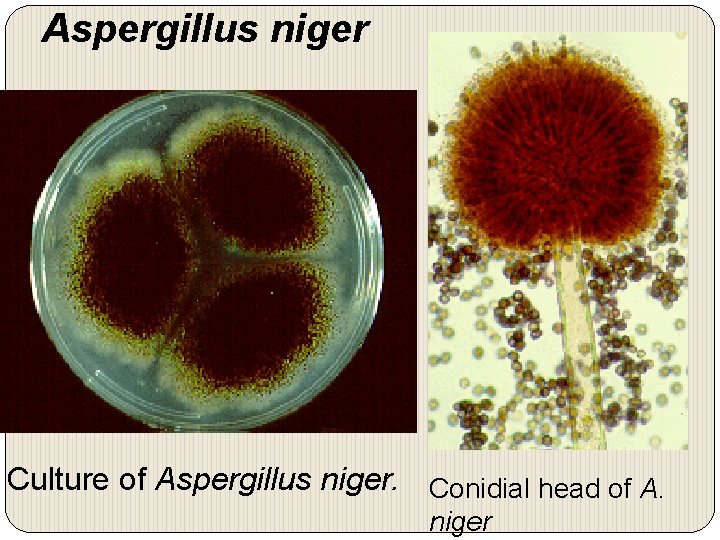
Aspergillus niger Culture of Aspergillus niger. Conidial head of A. niger

RESPIRATORY BLOCK Practical 2015 Streptococcus pyogenes Group A

RESPIRATORY BLOCK Practical 2015

Streptococcus pyogenes = Group A Strep Carried by 10 -25% of many in throat often no symptoms it is Cause of • strep throat • impetigo • Necrotizing fasciitis

Streptococcus pyogenes. = Group A Strept Left. Gram stain of Streptococcus pyogenes in a clinical specimen. Right. Colonies of Streptococcus pyogenes on blood agar exhibiting beta (clear) hemolysis

• Principle: – Bacitracin test is used for presumptive identification of group A – To distinguish between S. pyogenes (susceptible to B) & non group A such as S. agalactiae (Resistant to B) – Bacitracin will inhibit the growth of gp A Strep. pyogenes giving zone of inhibition around the disk • Procedure: – Inoculate BAP with heavy suspension of tested organism – Bacitracin disk (0. 04 U) is applied to inoculated BAP – After incubation, any zone of inhibition around the disk is considered as susceptible

Bacitracin sensitivity

Case 1 A 5 year boy was brought to king Khalid University hospital, outpatient department complaining of fever and sore throat. He had regular vaccination history. On examination his temperature was 38. 5° c, the tonsil area and pharynx were obviously inflamed with some foci of pus.

1. What is the differential diagnosis? 2. What investigation should be done?
• Lab tests • The full blood count showed a total white cell count of 15000 ml. Throat swab culture showed colonies with clear haemolysis on blood agar. They were catalase negative. The gram stain of these colonies showed gram positive cocci in chains

1. What is the likely identity of the organism? 2. What is the best antibiotic therapy for this child? 3. If not treated what complication may this child have after 6 weeks period?

Streptococcus pneumoniae (Pneumococci)
Alpha-hemolysis • Alpha-hemolytic Streptococcus species "Viridans group" streptococci, including species such as the Streptococcus mutans, mitis, and salivarius groups display alpha hemolysis.
Optochin Susceptibility Test Optochin resistant S. viridans Optochin susceptible S. pneumoniae
Optochin Sensitive

CASE 2 A 28 Year Old Female presented to the accident and emergency of KKUH with a sudden onset of fever, right sided chest pain and productive cough of purulent sputum. On examination her temperature was 39 °C. There were Rhonci and dullness on the right side of the chest. X-ray showed massive consolidation on the right side of the chest.

1. What is the most likely diagnosis? 2. What investigation should be done?

• LAB TESTS • The blood counts showed a total white cell count 45, 000/ ml 90% of the cells were neutrophils. The sputum culture showed alpha haemolytic colonies on blood agar. The gram stain showed gram positive diplococcic. which were catalase negative This organism was confirmed to be optician susceptible. 3. What should have been the empirical therapy for this case and why?

Sputum Microscopy Mycobacterium tuberculosis: Ziehl. Neelsen stain

Mycobacterium tuberculosis Growth on L. J medium( selective for mycobacteria

CASE 3 Abdul Karim is a 45 year old Saudi man who was admitted to King Khalid University Hospital because of 2 -3 month history of loss of appetite, weight loss, and on and off fever with attacks of cough. Two days before admission. he coughed blood (haemoptysis) Abdul karim is diabetic for the last 5 years. His father died of tuberculosis at the age of 45 yrs.

• On examination Abdul Karim looked weak with a temperature 38. 6 °C, CVS and Respiratory system examinnation was unremarkable. • The chest X- ray done showed multiple opacities and cavities • The ESR was increased (85 m /hour) • What further tests should be done?

• Sputum AFB smear • Sputum smear showed AFB • What is the probable diagnosis? • How can the diagnosis be confirmed?

Gram positive, cocci, in clusters

Staphylococci Stained in Pus

Vaginal Smear of a Person with Candida Vaginit Note epithelial cells, rod-shaped bacteria, and Candida albicans in its hyphal form is

Candida albicans Producing Germ tube Dimorphic Candida albicans switching from a yeast form to a filamentous form

Gram stain of candida: ovoid buding. Yeast Chlamydospore oral thrush Oral Candida or
Growth on Sabouraud's Dextrose Media

Gram stain of Candida albicans Showing budding yeast celols
Aspergillus niger Culture of Aspergillus niger. Conidial head of A. niger

Aspergillus niger

Aspergillosis Methenamine silver (GMS) stained tissue section of lung showing dichotomously branched
- Slides: 31